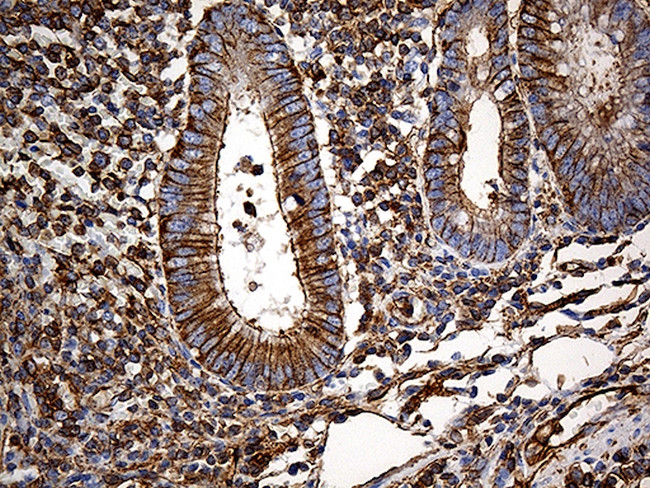
SPTAN1 Antibody in Immunohistochemistry (Paraffin) (IHC (P))

Search
OriGene
SPTAN1 Monoclonal Antibody (OTI9C10), TrueMAB™
{{$productOrderCtrl.translations['antibody.pdp.commerceCard.promotion.promotions']}}
{{$productOrderCtrl.translations['antibody.pdp.commerceCard.promotion.viewpromo']}}
{{$productOrderCtrl.translations['antibody.pdp.commerceCard.promotion.promocode']}}: {{promo.promoCode}} {{promo.promoTitle}} {{promo.promoDescription}}. {{$productOrderCtrl.translations['antibody.pdp.commerceCard.promotion.learnmore']}}
产品信息
TA812019
种属反应
宿主/亚型
分类
类型
克隆号
抗原
偶联物
形式
浓度
规格
纯化类型
保存液
内含物
保存条件
运输条件
靶标信息
SPTAN1 (spectrin alpha chain, non-erythrocytic 1) is a part of the spectrin family of filamentous cytoskeletal proteins. They function as essential scaffold proteins that stabilize the plasma membrane and organize intracellular organelles. Spectrins are composed of alpha and beta dimers that associate to form tetramers linked in a head-to-head arrangement. SPTAN1 has been implicated in other cellular functions including DNA repair and cell cycle regulation. Mutations in this gene are the cause of early infantile epileptic encephalopathy-5. Alternate splicing results in multiple transcript variants.
仅用于科研。不用于诊断过程。未经明确授权不得转售。
篇参考文献 (0)
生物信息学
蛋白别名: (ALPHA)II-SPECTRIN; alpha; alpha-fodrin; Alpha-II spectrin; alpha-spectrin; brain; epididymis secretory sperm binding protein; FLJ44613; Fodrin alpha chain; Non erythrocytic spectrin alpha; non-erythrocytic 1 (alpha-fodrin); non-erythroid alpha chain; nonerythroid alpha-spectrin; Spectrin; Spectrin alpha; Spectrin alpha chain brain; Spectrin alpha chain, non-erythrocytic 1; spectrin, non-erythroid alpha chain; Spectrin, non-erythroid alpha subunit; unnamed protein product
基因别名: DEE5; DEVEP; EIEE5; HMN11; HMND11; NEAS; SPG91; SPTA2; SPTAN1
UniProt ID: (Human) Q13813
Entrez Gene ID: (Human) 6709